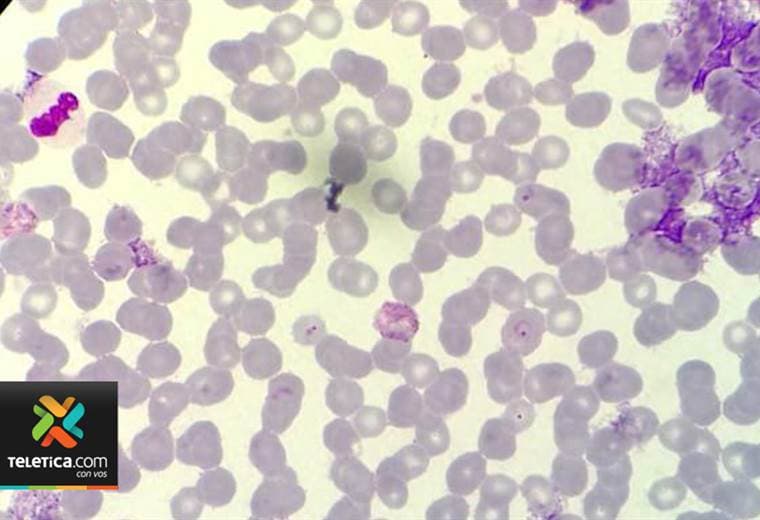
Examen de sangre conocido como 'La gota gruesa' permite diagnosticar la malaria

Examen de sangre conocido como “La gota gruesa” permite diagnosticar la malaria
La malaria provoca fiebre intermitente, escalofríos, sudoración, dolor de cabeza, dolor muscular.
Cuando aparecen los síntomas (fiebre intermitente, escalofríos, sudoración, dolor de cabeza, dolor muscular) el personal de la Caja Costarricense del Seguro Social (CCSS) debe sospechar y tramitar de inmediato un examen de laboratorio conocido como “La gota gruesa”.
Con la misma muestra de sangre se realiza un segundo examen que permitirá determinar qué especie de parásito tiene la persona, en caso de que “La gota gruesa” dé positivo.
Las muestras deben prepararse para su análisis: los microbiólogos utilizan un tinte de color morado.
Cuando el proceso se completa, los microbiólogos deben realizar el análisis en el microscopio.
El examen de “La gota gruesa”, para diagnosticar la malaria, se puede realizar en todas las clínicas y hospitales de la Caja.